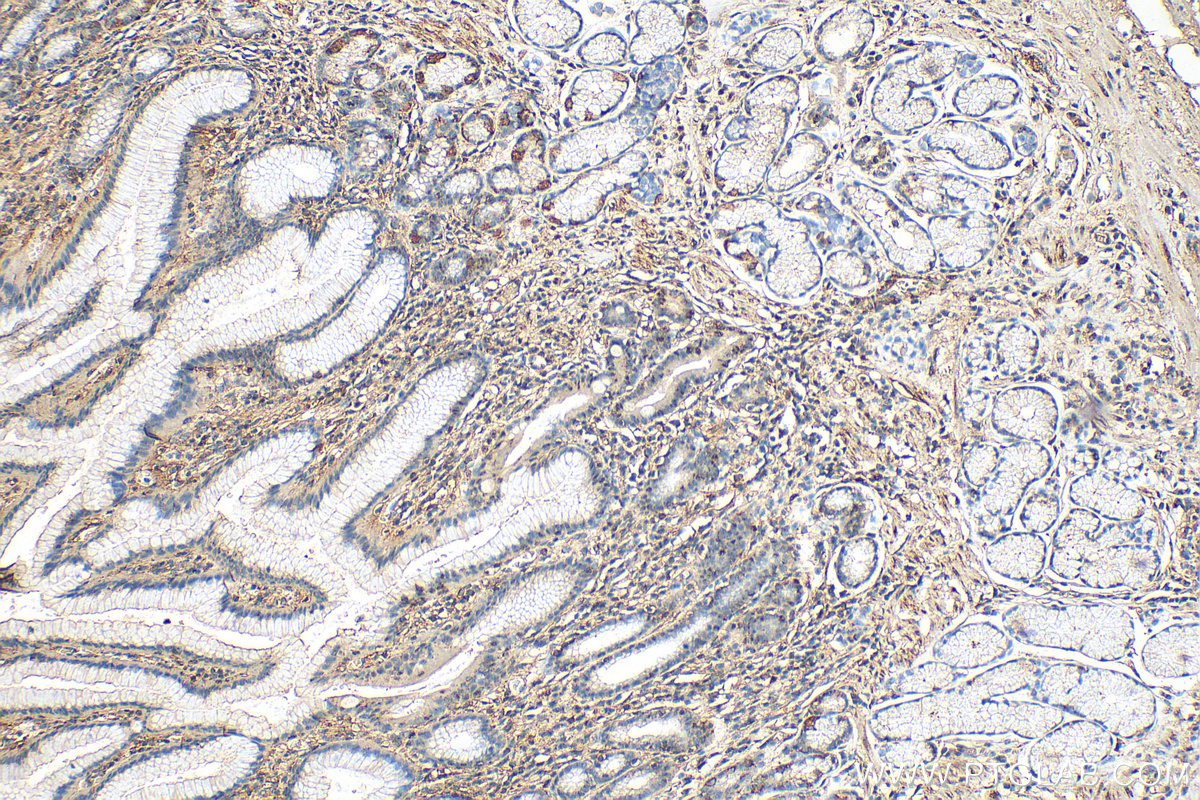
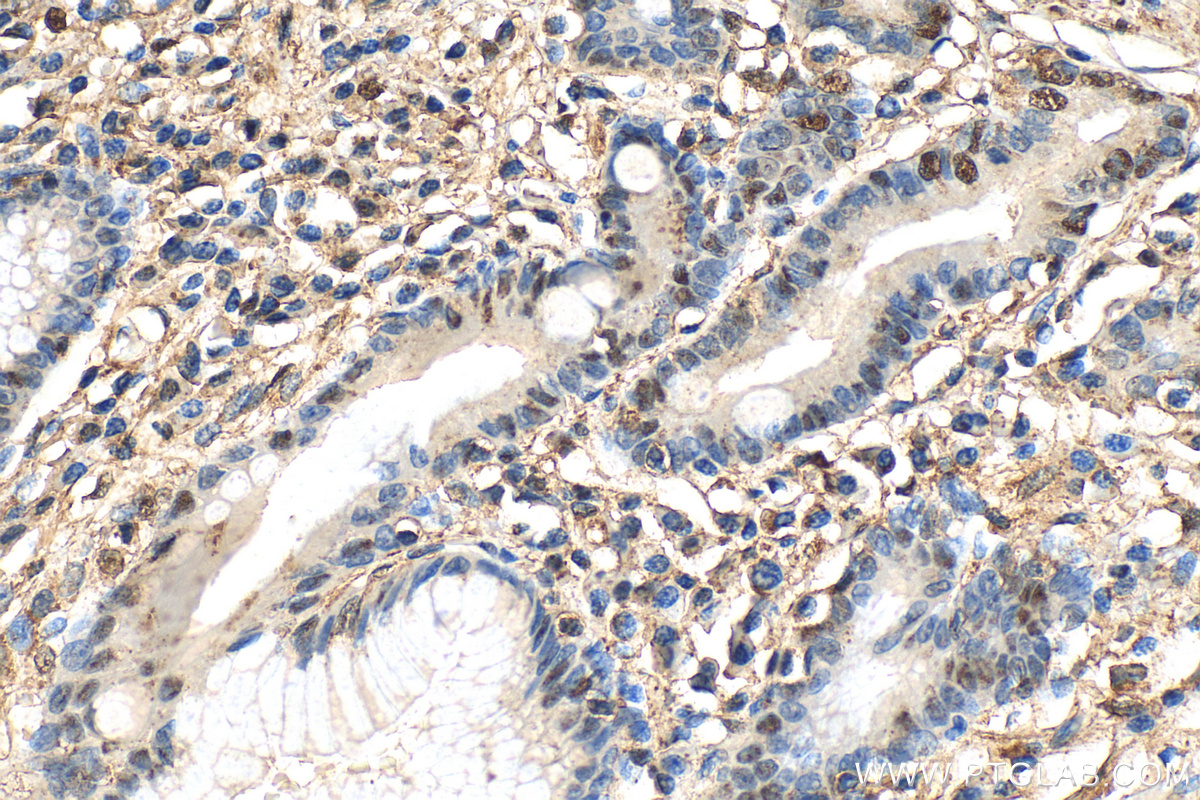

验证数据展示
经过测试的应用
| Positive WB detected in | A2780 cells, HeLa cells, human placenta tissue, A431 cells, C6 cells |
| Positive IP detected in | A2780 cells |
| Positive IHC detected in | human colon tissue, human placenta tissue, rat colon tissue, rat testis tissue Note: suggested antigen retrieval with TE buffer pH 9.0; (*) Alternatively, antigen retrieval may be performed with citrate buffer pH 6.0 |
推荐稀释比
| 应用 | 推荐稀释比 |
|---|---|
| Western Blot (WB) | WB : 1:2000-1:10000 |
| Immunoprecipitation (IP) | IP : 0.5-4.0 ug for 1.0-3.0 mg of total protein lysate |
| Immunohistochemistry (IHC) | IHC : 1:200-1:800 |
| It is recommended that this reagent should be titrated in each testing system to obtain optimal results. | |
| Sample-dependent, Check data in validation data gallery. | |
产品信息
20182-1-AP targets FSTL1 in WB, IHC, IF, IP, CoIP, ELISA applications and shows reactivity with human, rat samples.
| 经测试应用 | WB, IHC, IP, ELISA Application Description |
| 文献引用应用 | WB, IHC, IF, IP, CoIP |
| 经测试反应性 | human, rat |
| 文献引用反应性 | human, mouse, rat |
| 免疫原 |
CatNo: Ag14057 Product name: Recombinant human FSTL1 protein Source: e coli.-derived, PKG Tag: GST Domain: 1-308 aa of BC000055 Sequence: MWKRWLALALALVAVAWVRAEEELRSKSKICANVFCGAGRECAVTEKGEPTCLCIEQCKPHKRPVCGSNGKTYLNHCELHRDACLTGSKIQVDYDGHCKEKKSVSPSASPVVCYQSNRDELRRRIIQWLEAEIIPDGWFSKGSNYSEILDKYFKNFDNGDSRLDSSEFLKFVEQNETAINITTYPDQENNKLLRGLCVDALIELSDENADWKLSFQEFLKCLNPSFNPPEKKCALEDETYADGAETEVDCNRCVCACGNWVCTAMTCDGKNQKGAQTQTEEEMTRYVQELQKHQETAEKTKRVSTKEI 种属同源性预测 |
| 宿主/亚型 | Rabbit / IgG |
| 抗体类别 | Polyclonal |
| 产品类型 | Antibody |
| 全称 | follistatin-like 1 |
| 别名 | follistatin like 1, Follistatin like protein 1, Follistatin related protein 1, Follistatin-like protein 1, Follistatin-related protein 1 |
| 计算分子量 | 308 aa, 35 kDa |
| 观测分子量 | 35-40 kDa |
| GenBank蛋白编号 | BC000055 |
| 基因名称 | FSTL1 |
| Gene ID (NCBI) | 11167 |
| RRID | AB_10666439 |
| 偶联类型 | Unconjugated |
| 形式 | Liquid |
| 纯化方式 | Antigen affinity purification |
| UNIPROT ID | Q12841 |
| 储存缓冲液 | PBS with 0.02% sodium azide and 50% glycerol, pH 7.3. |
| 储存条件 | Store at -20°C. Stable for one year after shipment. Aliquoting is unnecessary for -20oC storage. |
背景介绍
Follistatin-like 1 (FSTL1), initially discovered as a TGF-β1-induced gene, encodes a 308 amino acid secreted 45-55 kDa glycoprotein with a follistatin domain and two non-functional calcium-binding motifs. FSTL1 has been reported to be involved in the fate determination and maturation of epithelial cells. Ablation of the FSTL1 gene in the mouse results in several structural developmental defects and neonatal lethality due to respiratory failure, demonstrating its functional importance. FSTL1 has been reported to exhibit both pro- and anti-inflammatory actions, with a specific anti-apoptotic and protective effect in cardiac or renal cell injury. Zwijsen et al. (1994) detected several isoforms of FSTL1 with molecular masses of 40 to 48 kD which differs from the 50- to 55-kD products detected by Tanaka et al. (1998) (OMIM). (PMID: 26386648; PMID: 23723173; PMID: 20176958).
实验方案
| Product Specific Protocols | |
|---|---|
| IHC protocol for FSTL1 antibody 20182-1-AP | Download protocol |
| IP protocol for FSTL1 antibody 20182-1-AP | Download protocol |
| WB protocol for FSTL1 antibody 20182-1-AP | Download protocol |
| Standard Protocols | |
|---|---|
| Click here to view our Standard Protocols |
发表文章
| Species | Application | Title |
|---|---|---|
J Exp Med EGF hijacks miR-198/FSTL1 wound-healing switch and steers a two-pronged pathway toward metastasis. | ||
Bone Res Single cell analysis reveals inhibition of angiogenesis attenuates the progression of heterotopic ossification in Mkx-/- mice. | ||
Cancer Res Follistatin-like Protein 1 Inhibits Lung Cancer Metastasis by Preventing Proteolytic Activation of Osteopontin.
| ||
Cell Death Dis FSTL1 interacts with VIM and promotes colorectal cancer metastasis via activating the focal adhesion signalling pathway. | ||
Aging (Albany NY) Follistatin-like 1 deficiency impairs T cell development to promote lung metastasis of triple negative breast cancer.
| ||
Am J Cancer Res FSTL1 promotes growth and metastasis in gastric cancer by activating AKT related pathway and predicts poor survival.
|